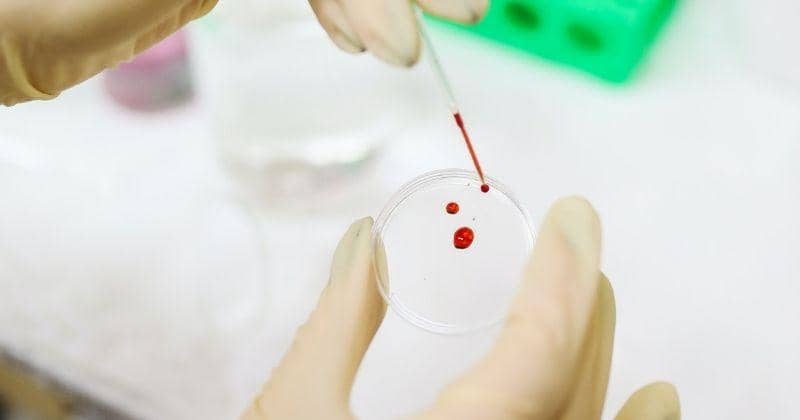
Pexels/Polina Tankilevitch

- kromosom hilang,
- inversi di mana kromosom terbalik,
- mutasi di mana ada perubahan dalam urutan DNA gen,
- aneuploidy dimana ada terlalu banyak atau terlalu sedikit kromosom,
- translokasi dimana potongan kromosom dilampirkan pada kromosom yang salah.
Bagaimana Faktor Genetik Memengaruhi Kesuburan Pasangan?

Bagi pasangan suami istri, memiliki keturunan adalah hal yang sangat penting. Karena itu, beragam cara dilakukan untuk meningkatkan kesuburan dan peluang hamil.
Kesuburan ditentukan oleh beragam faktor, namun apakah ini juga dipengaruhi oleh faktor genetik?
Dilansir dari ncbi.nlm.nih.gov, menurut sebuah penelitian, diperkirakan sekitar 50 persen kasus infertilitas disebabkan oleh masalah genetik. Sejarah keluarga memainkan peran yang dapat menyebabkan infertilitas. Selain itu, para ilmuwan masih bekerja untuk menemukan bagaimana lagi genetika dapat memengaruhi masalah kesuburan.
Bagaimana faktor genetik memengaruhi kesuburan pasangan? Penjelasannya dapat Mama simak pada ulasan Popmama.com berikut ini.
Faktor Genetik yang Mengatur Kesuburan Laki-Laki dan Perempuan

Pasangan yang mengalami infertilitas sering dapat dikaitkan dengan faktor genetik. Dari kelainan kromosom mewarisi dengan mutasi gen, baik laki-laki dan perempuan memiliki hasil yang berbeda dari kedua faktor ini. Ini termasuk:
Gangguan Genetik yang Menyebabkan Infertilitas Perempuan

Jika ada kasus endometriosis atau menopause dini dalam keluarga, kemungkinan Mama juga bisa mengalaminya.
Beberapa kelainan kromosom atau mutasi gen dapat menyebabkan infertilitas perempuan, terutama mempengaruhi kemampuan untuk berovulasi. Contoh keduanya meliputi:
- Mutasi dalam gen fibrosis kistik dapat mengakibatkan perempuan dengan nutrisi yang buruk, menghasilkan mukus serviks yang lebih tebal atau masalah ovulasi.
- Kallmann Syndrome dapat menyebabkan infertilitas perempuan karena ketidakmampuan tubuh untuk menghasilkan hormon hipofisis atau hipotalamus.
- Dyskinesia ciliary primer adalah infeksi saluran pernapasan kronis (penyakit pada saluran udara atau bagian paru-paru) yang menyebabkan infertilitas pada perempuan dari silia abnormal di tabung fallopi.
Gangguan Genetik yang Menyebabkan Infertilitas Laki-Laki

Beberapa kelainan kromosom atau mutasi gen menyebabkan infertilitas laki-laki, terutama memengaruhi produksi atau menghalangi aliran sperma. Namun, infertilitas laki-laki karena mutasi jauh lebih jarang atau tidak dipahami pada tingkat yang lain. Contoh keduanya meliputi:
- Mutasi dalam gen fibrosis kistik dapat mengakibatkan tidak adanya kongenital vas deferens yang mempengaruhi aliran sperma.
- Sindrom Klinefelter adalah suatu kondisi yang dialami oleh laki-laki ketika mereka dilahirkan dengan kromosom X ekstra yang memengaruhi produksi sperma dan testosteron.
- Y Penghapusan kromosom (bagian yang hilang dari kromosom Y) dapat menyebabkan laki-laki tidak dapat mencapai jumlah sperma normal.
Infertilitas jarang dapat dikaitkan semata-mata untuk faktor genetik. Dalam kebanyakan kasus, ada beberapa penyebab infertilitas. Semakin banyak penyebab ini yang dapat diidentifikasi dan ditangani, semakin besar kemungkinan pengobatan infertilitas akan efektif. Untungnya, perawatan infertilitas sudah semakin berkembang. Bahkan faktor genetik sekarang sering dapat diatasi dengan protokol perawatan yang tepat.
Apakah Mama dan Papa Harus Melakukan Tes Darah Genetik?
Sebelum menjalani IVF atau perawatan kesuburan lainnya, pasangan suami istri disarankan untuk menjalani tes darah. Diagnosis genetik preimpplantasi (PGD / PGS / PGT-A) sering dapat digunakan untuk mencegah munculnya gangguan genetik ketika digunakan bersamaan dengan IVF.
Beberapa penggunaan untuk PGD / PGS / PGT-A meliputi:
- menemukan segala kondisi kesehatan bawaan yang mungkin tidak disadari
- mempelajari tentang kondisi genetik saat ini yang dapat memengaruhi kemampuan untuk hamil
- mitigasi risiko menurunkan gangguan genetik pada anak kelak
Jadi, faktor genetik memengaruhi kesuburan pasangan ya, Ma. Jika Mama sudah berusaha untuk hamil selama enam bulan sampai setahun namun belum berhasil, jangan ragu untuk memeriksakan diri ke dokter. Penting untuk diketahui kalau masalah kesuburan bukanlah masalah perempuan saja ya, Ma. Jadi sebaiknya lakukan pemeriksaan kesuburan bersama papa juga.



















